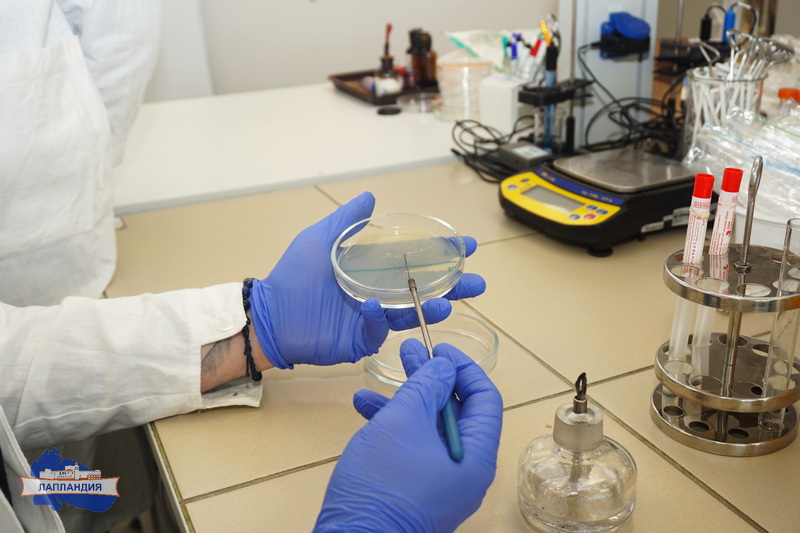
Полным ходом идёт подготовка финалиста регионального чемпионата «Профессионалы»!

Полным ходом идёт подготовка финалиста регионального чемпионата «Профессионалы»!
С 22 по 26 апреля в г. Оренбурге состоится итоговый этап Чемпионата по профессиональному мастерству «Профессионалы-2025» по компетенции «Лабораторный медицинский анализ» (юниоры).
Наш финалист в категории юниоров Эрнест Мельников ведет интенсивную подготовку по всем модулям конкурсного задания!
Так, под руководством опытного врача-бактериолога Мурманской областной клинической больницы им. П.А. Баяндина Евгения Халяпина был проведен специализированный мастер-класс по выполнению посева для диагностики дифтерийной инфекции (модуль Б контрольного задания).
Подготовка осуществляется на базе Биоквантума, где созданы все условия для качественного освоения как теоретической части, так и практических аспектов лабораторной диагностики.
Желаем нашему участнику успешного выступления на заключительном этапе чемпионата!